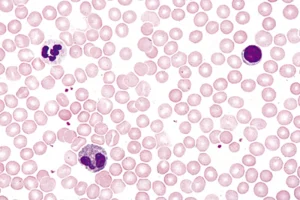
Human blood, microscope slide

All Products
Hooke’s Law Spring Set
Hooke’s Law Spring SetIncludes three springs with the same diameter and length, but different spring constants.
Hooked Mass Set
Hooked Mass SetA rugged cast-iron mass set that is coated with enamel.
Hookes Law
Hookes LawThis apparatus from Lascells provides a robust and convenient method of verifying Hooke’s law.
Horseshoe magnet
Horseshoe magnetU-shaped and strong AIniCo magnet with colored poles. Equipped with anchor.
Horseshoe magnet, large
Horseshoe magnet, largeU-shaped and strong AIniCo magnet with colored poles. Equipped with anchor.
Hose for Air Blower
Hose for Air BlowerUsed to connect the air track to the air blower. Spare part – included with the blower.
Hover Puck
Hover PuckThe Hover Puck glides on a self-generated cushion of air across any smooth surface, including low-pile carpet. The rubber bumper provides protection for the puck and other objects during collisions. (Appearance may vary)
Hovercraft
HovercraftExperience frictionless motion to better understand Newton’s Laws. Students can easily ride on the hovercraft to experience it for themselves.
Hovering magnets, Multicoloured
Hovering magnets, MulticolouredSix magnets on a plastic stick with a foot.
A simple and colorful way to demonstrate the power of magnets. With the 6 magnets, you can also illustrate the pressure change up through the atmosphere.
Hovering magnets, Two-coloured
Hovering magnets, Two-colouredThree PCS. two-coloured magnets on plastic stick with foot. A simple and colorful way to demonstrate the power of magnets.
Human Arm Model
Human Arm ModelMechanical model that simulates the muscles and motion of an actual human arm. To activate the motion students pull on the cord.
Human blood, microscope slide
Human blood, microscope slideThe microslide shows a blood smear of human blood that has been fixed and stained so that the different blood cells can be clearly distinguished. The red blood cells appear red, while the white blood cells are seen in purple-blue shades with different sizes and nuclear types. The slide provides a clear insight into the composition of the blood and makes it possible to work with both the structure and function of the individual cell types.
Human Eye Model
Human Eye ModelPlastic lenses create images for normal vision, far-sightedness, near-sightedness and astigmatism. Additional lenses are placed in front of the eye to correct for vision problems.
Human Structures Set
Human Structures SetSet of structures equipment which allows for construction and demonstration of Human Arm, Human Leg and Human Back Models.
Hydraulic press model
Hydraulic press modelTwo syringes of volumes 2 and 20 mL connected by a short PVC tube. The difference in diameter of the syringes illustrates the hydraulic press principle.
Ice Melting Blocks
Ice Melting BlocksOne block feels cold to the touch while the other block feels slightly warm. Both blocks are at room temperature but have very different thermal conductivities.
Ice Molecule model
Ice Molecule modelMolecular model of “Ice”.
Contains 105 nuclear balls and 130 connecting links.
The model is delivered unassembled, but with assembly instructions.
Ideal Gas Law – Wireless
Ideal Gas Law – WirelessIn this experiment designed for use with PASCO Capstone software, the temperature, volume, and pressure of a gas are measured simultaneously to show that they change according to the Ideal Gas Law.